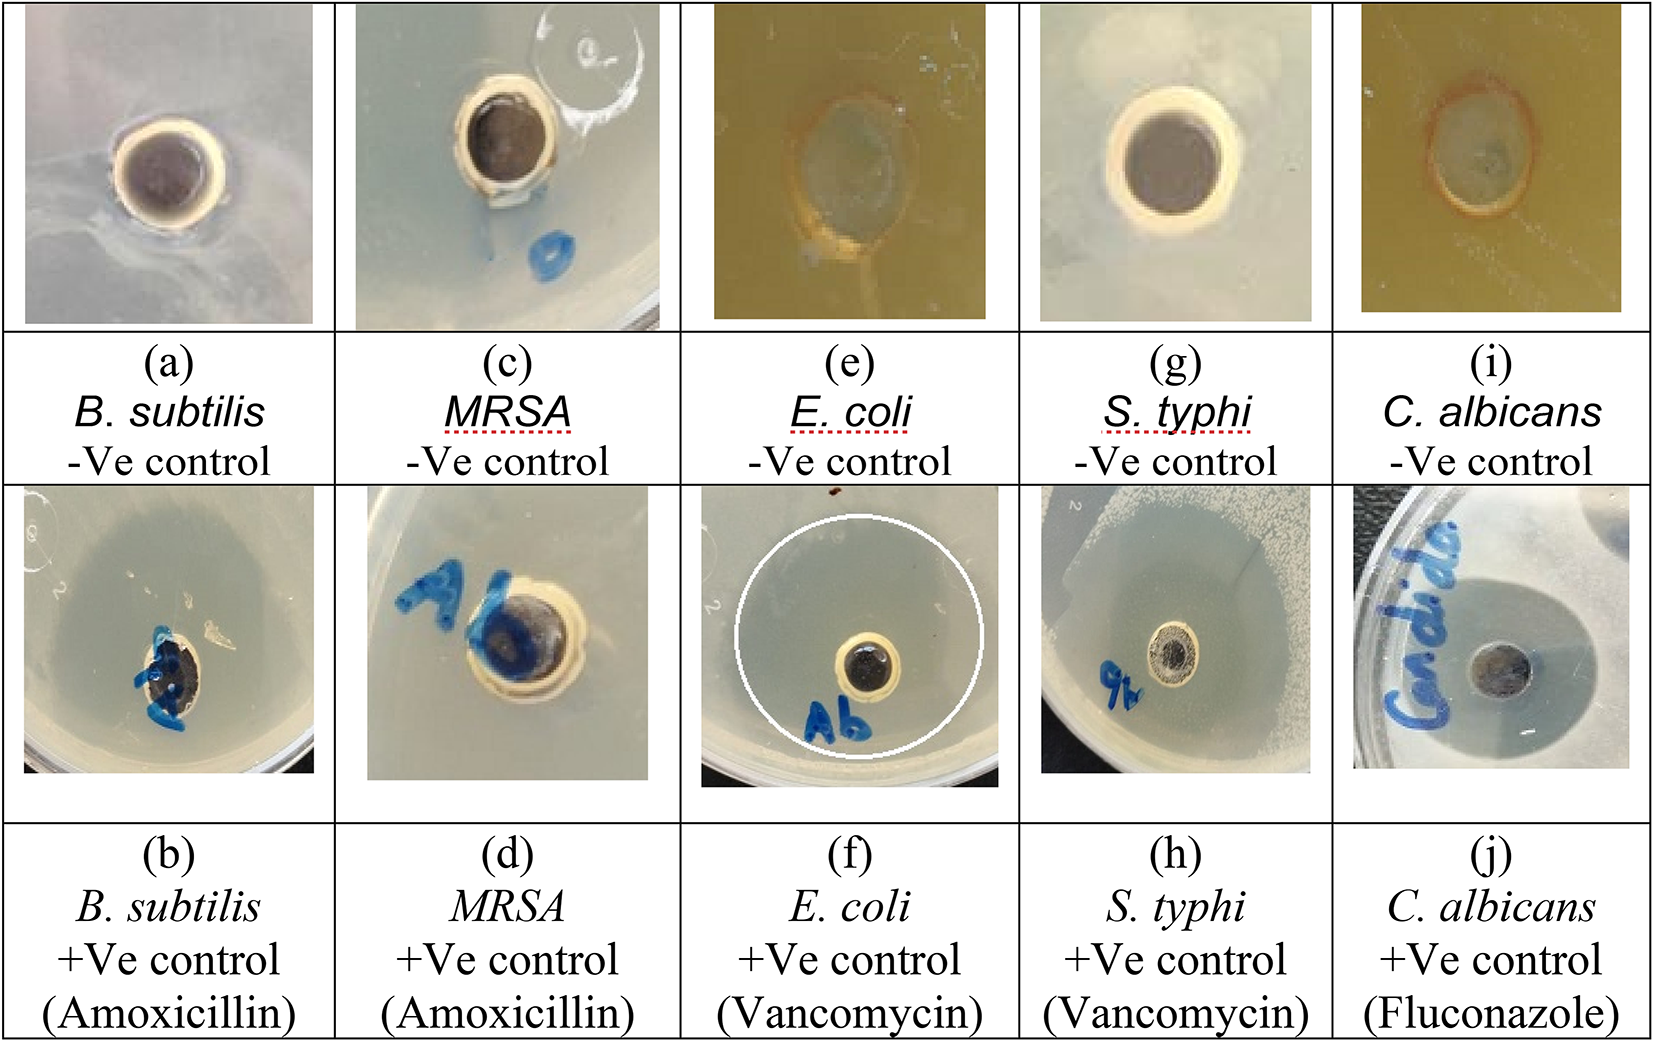
Fig. 9

Fig. 9

Antimicrobial activity of the + Ve control (antibiotics, i.e., Amoxicillin and Vancomycin for + Gram bacteria and -Gram bacteria, respectively) and FFE (-Ve control) samples against the pathogenic bacterial and fungal isolates.
Antimicrobial activity of the + Ve control (antibiotics, i.e., Amoxicillin and Vancomycin for + Gram bacteria and -Gram bacteria, respectively) and FFE (-Ve control) samples against the pathogenic bacterial and fungal isolates.